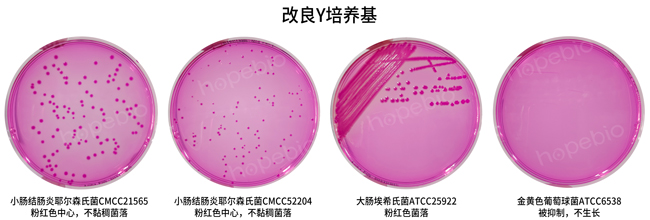

用途:用于分离小肠结肠炎耶尔森氏菌(GB标准)。
成分(g/L)
蛋白胨
|
15.0
|
氯化钠
|
5.0
|
乳糖
|
10.0
|
草酸钠
|
2.0
|
去氧胆酸钠
|
6.0
|
三号胆盐
|
5.0
|
丙酮酸钠
|
2.0
|
孟加拉红
|
0.04
|
水解酪蛋白
|
5.0
|
|
琼脂
|
17.0
|
pH值7.4±0.1
|
25℃
|
检验原理:
蛋白胨、水解酪蛋白在培养基中作为营养物质提供菌体细胞生长所需要的氮源、碳源及生长因子等;氯化钠维持培养基体系渗透压;乳糖作为可发酵的碳水化合物;三号胆盐和去氧胆酸钠抑制革兰氏阳性菌生长;丙酮酸钠和草酸钠能促进目标菌生长;孟加拉红作为着色剂;琼脂作为凝固剂。
用法:
称取本品67.0g,加热溶解于1000ml蒸馏水中,分装,121℃高压灭菌15分钟,待冷至45-50℃时,倾入无菌平皿。
不同细菌在改良Y培养基上的生长特征:

改良Y培养基微生物质控结果:
改良Y培养基微生物灵敏度试验:
按标签用法制备培养基,接种以下质控菌株,放置26±1℃需氧培养48±2小时。

相关文章:
改良Y培养基原理和使用方法 点击查看
小肠结肠炎耶尔森氏菌检验方法及结果分析 点击查看


 海博微信公众号
海博微信公众号
 海博天猫旗舰店
海博天猫旗舰店


 海博微信公众号
海博微信公众号
 海博天猫旗舰店
海博天猫旗舰店






